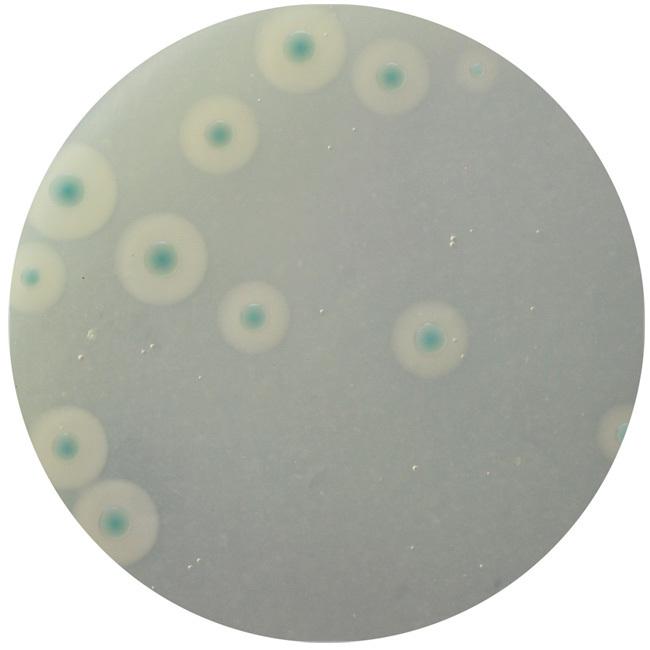
图片
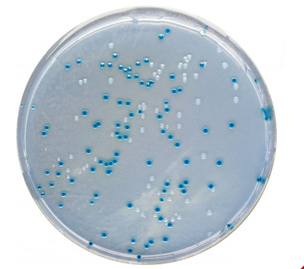
图片

2021-09-06 13:58浏览量:940
目前, 微生物的检验方法是以培养法作为标准, 通过对食品样品预增菌、选择性增菌、分离培养、生化鉴定、血清分型等手段, 实现食品中致病微生物定性和定量检测, 检验流程通常为 3~7 天。但此类方法操作烦琐、耗时长, 企业实际样本检测中, 大部分食品样本尤其是预包装食品检测结果几乎都是阴性, 因而需要一种简单、快速、方便、低成本的检验方法进行初筛, 出现阳性、疑似阳性再进一步用培养法进行分类鉴定, 提高检测效率。近些年, 随着国际交流合作的开展, 标准的进步, 我国科研水平的提高, 相继出现了许多快速检测及鉴定技术和产品。
接下来,小编为您介绍几种食品中微生物检测常用的快速检测技术!
01 微生物测试片法

测试片主要由培养基、冷水可凝胶、显色剂等组成。显色剂由微生物代谢物质、显色基团组成, 微生物生长过程中的代谢产生的酶与显色底物发生反应而显色。与显色培养基原理一致。
测试片形式:目前测试片有以冷水凝胶、无纺布、滤纸等为载体的几种形式。
检测项目: 菌落总数、大肠菌群、霉菌酵母、金黄色葡萄球菌、大肠杆菌、沙门氏菌、环境李斯特菌等。
方法优势:测试片具有操作简单、判读清晰、降低误差、提高效率等优势, 检测过程无需配置试剂, 提高工作效率并有效降低实验误差, 可以在 24~48 h 内完成检测; 结果判读以菌落显色为依据, 相比传统培养基更容易计数, 很适合实验室使用。可定量检测,也可定性检测。

02 免疫胶体金技术

胶体金检测卡应用“双抗体夹心法”的原理, 目标致病菌和金标记的特异性单克隆抗体结合及预包备于 NC 膜 T线位置的特异性多克隆抗体结合, 金颗粒的聚集而显示明显的红线。通过肉眼直接观察是否出现 T 线, 判断样品中是否含有目标菌。
检测时, 滴加增菌液 10 min 左右即可进行结果判读, 适合用于大量样本快速筛查。本方法仅适用于致病菌定性检测。

03 荧光定量PCR技术

荧光定量 PCR 技术,是在 PCR 扩增过程中,通过荧光信号,对 PCR 进程进行实时检测。由于在 PCR 扩增的指数时期, 模板的 Ct 值和该模板的起始拷贝数存在线性关系, 成为定量的依据。与传统 PCR 相比,荧光定量 PCR 产物无需电泳即可实时观察定量, 反应快速,灵敏度高,目前已经在医疗诊断领域获得广泛应用, 食品安全领域近些年刚起步, 主要用于食源微生物、食品过敏源、转基因等项目的检测。
此外,还有等温PCR 技术、数字 PCR 技术、免疫 PCR、核酸杂交技术、微流控芯片技术等, 其中主要应用于食品检测的是荧光定量 PCR 技术。

04 显色培养基法

不同致病菌在代谢过程中能够产生的特异性的酶, 通过在培养基中加入相应的底物和指示剂, 在细菌生长过程中产生荧光或显示一定颜色, 利用紫外灯观察细菌产生的荧光或直接观察菌落颜色, 可以把检测、计数和鉴定一次完成。
这种技术将传统的致病菌分离与生化反应鉴定有机的结合起来, 且检测结果直观, 因此显色培养基技术正成为目前微生物快速检测的主流技术。检测的酶主要有: 糖苷酶、酯酶、脂酶、DNA 酶、蛋白酶和磷酸酶。可定量检测,也可定性检测。
05 实时光电检测法

实时光电法一般由具有温度控制和光学探测的仪器、分析软件及配套的检测试剂盒(包括特异性的检测培养基与专用指示剂)组成。 通过监控微生物生长代谢带来的pH 值改变及其他生物学反应来进行检测和判断。微生物的代谢产物使培养基的化学特性及试剂颜色发生改变, 光学系统对上述化学变化产生的光度改变进行实时监控, 微生物含量越高, 检出时间越快。
对于高菌量样本,检测时间短,6-18h,快速生成报告,数据可自动存储和即时追踪,减少存货压力。但无法像测试片一样直接得到CFU的结果。
06 质谱鉴定技术

质谱是一种新型的微生物鉴定方法, 可以快速对已知菌和未知菌进行鉴定, 其原理是质谱仪离子源通过电离效应给予了待检测目标菌较高的能量, 目标菌吸收能量后被激发, 产生强烈的离子化效能,之后被载气带入质谱仪, 通过电压的作用加速飞行, 由于各个离子间具有不同的质荷比, 会按照质量数的大小被分离, 被捕获后的带电粒子在检测器上产的信号信息也各不相同, 通过与质谱库中标准图谱数据信息进行比对, 来实现对细菌的鉴定。MALDI-TOF 技术能够迅速有效的对于微生物的种类进行鉴定, 但该技术也有一定局限性, 一般依靠细菌图谱的参考对于细菌的种类进行鉴定, 需要不断完善图谱数据库。
虽然已经发展了诸多的食源性微生物快速检测方法, 这些方法都有各自的优点和缺点, 每种方法都有自己适用的对象和环境。但这些方法仍然面临食品本身性质与检测要求的挑战, 因此, 为了保障食源性微生物安全, 未来还应该加大对食源性微生物快速检测技术研究, 开发更准确、更快速、更简单的食源性微生物快速检测技术与产品。
内容来源:
[1]姬莉莉, 闫雪.食品中微生物限量要求及检测技术发展趋势[J].食品安全质量检测学报, 2021, 12(02):459-465.
[2]陈爱亮.食品安全快速检测技术现状及发展趋势[J].食品安全质量检测学报,2021,12(02):411-414.
声明:部分图片来自网络,版权归原作者所有,若侵权,请联系删除 。
上一篇: 吃“小零食”肉毒杆菌中毒?是其产生的肉毒毒素在作妖!
下一篇: 关于“秋粮安全”的那些事儿